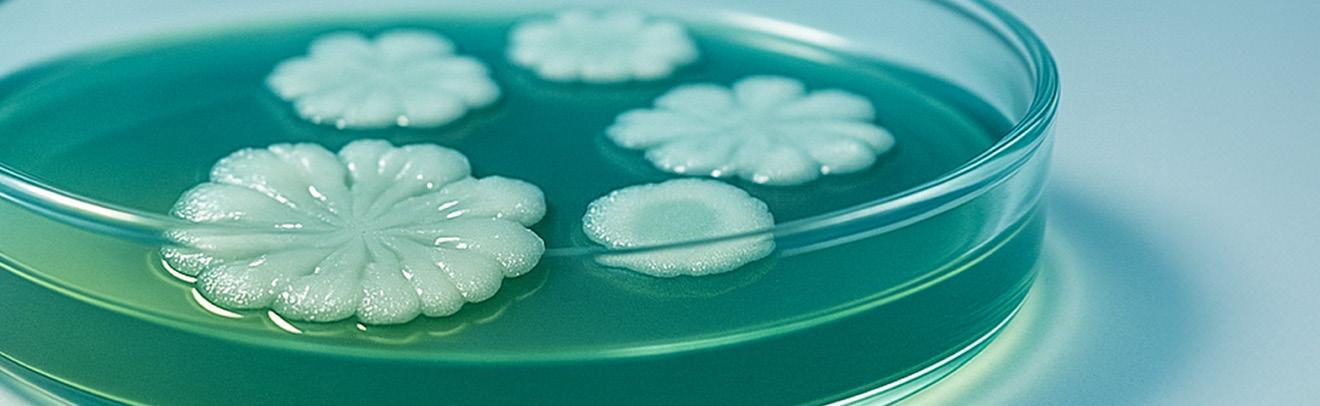

Está no ar a segunda edição do #BioJournal, publicação que reúne as principais novidades, lançamentos e acontecimentos da Koppert na América do Sul, em 2025.
Nesta edição, nossa revista apresenta os highlights da XIII Convenção - Raiz & Conexão, que aconteceu em Piracicaba (SP), a recente migração das nossas operações industriais para o mercado livre de energia elétrica no Brasil, parcerias estratégicas com o IAC (Instituto Agronômico de Campinas) e a Croplife Brasil, por meio do Projeto Bioinsumos Brasil, e outros conteúdos exclusivos que impulsionam o nosso setor.
Boa leitura!